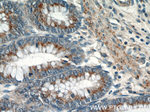
GOLPH3 Antibody in Immunohistochemistry (Paraffin) (IHC (P))

Search
Proteintech
GOLPH3 Polyclonal Antibody
{{$productOrderCtrl.translations['antibody.pdp.commerceCard.promotion.promotions']}}
{{$productOrderCtrl.translations['antibody.pdp.commerceCard.promotion.viewpromo']}}
{{$productOrderCtrl.translations['antibody.pdp.commerceCard.promotion.promocode']}}: {{promo.promoCode}} {{promo.promoTitle}} {{promo.promoDescription}}. {{$productOrderCtrl.translations['antibody.pdp.commerceCard.promotion.learnmore']}}
产品信息
19112-1-AP
种属反应
已发表种属
宿主/亚型
分类
类型
抗原
偶联物
形式
浓度
规格
纯化类型
保存液
内含物
保存条件
运输条件
产品详细信息
Immunogen sequence: MTSLTQRSS GLVQRRTEAS RNAADKERAA GGGAGSSEDD AQSRRDEQDD DDKGDSKETR LTLMEEVLLL GLKDREGYTS FWNDCISSGL RGCMLIELAL RGRLQLEACG MRRKSLLTRK VICKSDAPTG DVLLDEALKH VKETQPPETV QNWIELLSGE TWNPLKLHYQ LRNVRERLAK NLVEKGVLTT EKQNFLLFDM TTHPLTNNNI KQRLIKKVQE AVLDKWVNDP HRMDRRLLAL IYLAHASDVL ENAFAPLLDE QYDLATKRVR QLLDLDPEVE CLKANTNEVL WAVVAAFTK (1-298 aa encoded by BC033725 )
靶标信息
GOLPH3 was initially identified as a peripheral membrane protein localized to the trans-Golgi network, but others reported it to be primarily a mitochondrial protein that regulated the mitochondrial mass through the regulation of the mitochondria-specific phospholipid cardiolipin. GOLPH3 has since been implicated in the target of rapamycin (TOR) signaling pathway. Its overexpression in transfected cells led to and increase in anchorage-independent growth and cell proliferation in vitro. Furthermore, GOLPH3-transfected cells enhanced S6 Kinase activity in response to growth factor stimulation by EGF. Simultaneously, AKT phosphorylation increased in these cells, while these events were abrogated in GOLPH3 siRNA treated cells compared to control cells, indicating the GOLPH3 can enhance signaling through TOR-associated complexes. These results suggest that GOLPH3 is a bona fide oncogene and may be a useful target for therapeutic strategies.
仅用于科研。不用于诊断过程。未经明确授权不得转售。
生物信息学
蛋白别名: Coat protein GPP34; coat-protein; golgi peripheral membrane protein 1, 34 kDa; Golgi phosphoprotein 3; golgi protein; golgi-associated protein; MIDAS; Mitochondrial DNA absence factor; trans-Golgi protein GMx33; unnamed protein product
基因别名: 4733401N08Rik; 5730410D03Rik; AW413496; Gmx33; GOLPH3; GOPP1; GPP34; MIDAS; Vps74
UniProt ID: (Human) Q9H4A6, (Mouse) Q9CRA5
Entrez Gene ID: (Human) 64083, (Mouse) 66629, (Rat) 78961